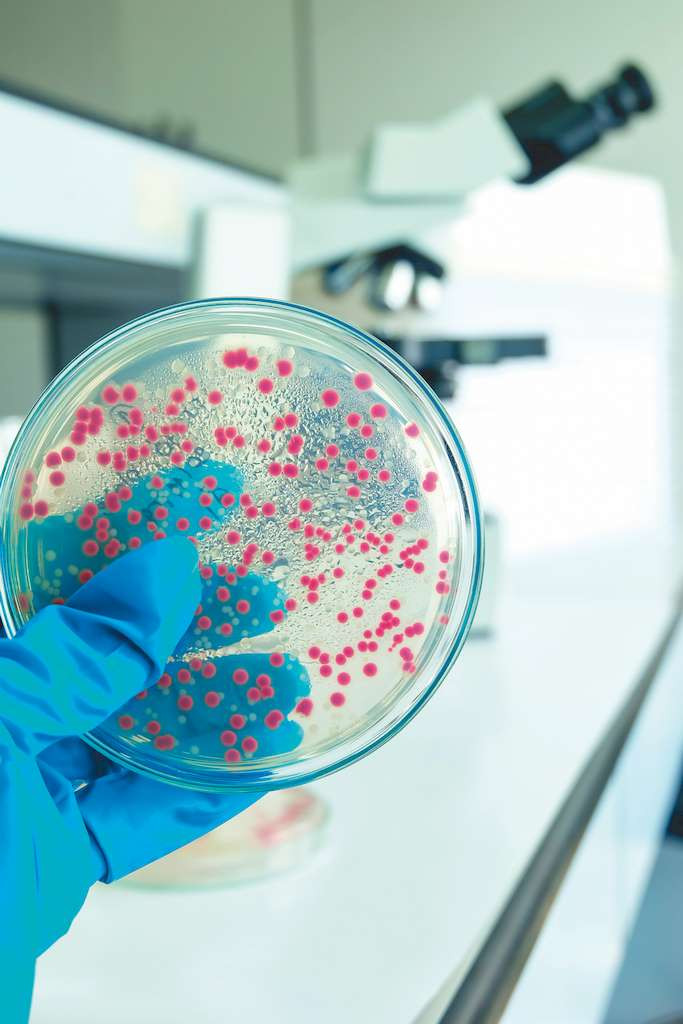

Медицинские новости
Что делает бактерии особо опасными?
Почему одни патогенные бактерии могут вызывать тяжёлые заболевания, а другие относительно безвредны? Например, некоторые бактерии E. coli могут вызывать опасный для жизни сепсис, неонатальный менингит, в то время как другие представители этого же вида живут в организме, не причиняя вреда. Исследователи из Университета Квинсленда выяснили, что это связано со способностью бактерии производить целлюлозу. При нарушении выработки этого полисахарида усиливается передача врождённых иммунных сигналов в теле пациента, что приводит к повышенной проницаемости кишечника и дальнейшему распространению E. coli в организме. Поскольку угроза супербактерий, устойчивых ко всем доступным антибиотикам, в мире возрастает, поиск новых способов борьбы с ними имеет решающее значение. Учёные надеются, что в будущем их открытие может помочь в борьбе с устойчивостью к антибиотикам.
